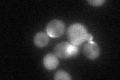
YHL007C
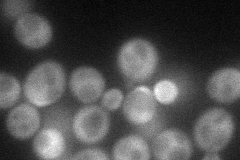
YHL007C
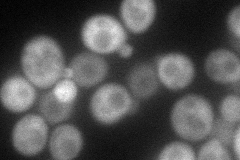
YHL007C
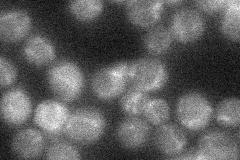
YHL007C
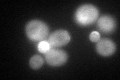
YHL007C
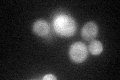
YHL007C
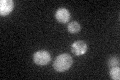
YHL007C

View description
Cdc42p-activated signal transducing kinase of the PAK (p21-activated kinase) family, involved in pheromone response, pseudohyphal/invasive growth, and vacuole inheritance; GBB motif (found in noncatalytic domains of PAKs) binds Ste4p
Localization:
Intensity:
Fold change:
Significance:
-
C’ GFP library in SD
cytosol:bud neckN/A -
N' NOP1pr-GFP in SD
cytosol,bud63.4991 -
N' TEF2pr-mCherry in SD
bud71.2774 -
N' NATIVEpr-GFP in SD
ambiguous,bud neck25.155 -
N' TEF2pr-VC and Cyto-VN in SD

cytosol46.6627 -
C’ GFP library in SD+DTT
cytosol.bud neck54.991.11No -
C’ GFP library in SD+H2O2
cytosol.bud neck52.531.06No -
C’ GFP library in Starvation Media
cytosol,bud neck39.690.8No -
C’ GFP library on the background of Pup2-DaMP

cytosol:bud neck -
C’ GFP library on the background of CCT mutant

cytosol:bud neck51.96611.05206No
